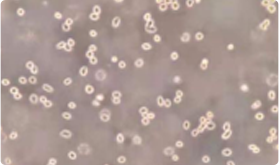

返校开学啦,从不言败的科研人回到实验室继续为实验奋斗了,新学期的Flag是实验数据又快又准,实验试剂到货神速,文章发表多多益善。要想Flag屹立不倒,赛业OriCell®助你披荆斩棘,实验硬装备——细胞及培养试剂开学优惠开心趴,以超高性价比的价格即可享受高品质的追求!赛业产品和技术服务已直接应用于包括CNS(Cell、Nature、Science)三大期刊在内的5240余篇学术论文,款款爆品,众多科研用户的信赖之选。如需 咨询订购,欢迎拨打400-680-8038 或邮件至info@oricellbio.cn。
活动时间:2021年9月1日——2021年10月31日
活动对象:科研终端客户
活动内容:
① 订购OriCell®干细胞、培养基、细胞冻存液及细胞因子等全品类产品,购买任意一款立享八折优惠!
② 订购OriCell®进口胎牛血清满五瓶,再赠送一瓶!
赛业OriCell®旗下拥有规模庞大、品类齐全的科研干细胞库,可提供间充质干细胞、胚胎干细胞、神经干细胞等多种干细胞产品,间充质干细胞来源丰富,包含人、大鼠、小鼠、兔、狗等多种种属的骨髓和脂肪组织等来源,全力满足你的不同研究需求。OriCell®干细胞产品均经过细菌、真菌、支原体检测,表达干细胞特异性标记,具有良好的增殖分化潜能。现OriCell®干细胞产品任购一款即享八折优惠,快把高质量干细胞带回实验室吧!
| 细胞类型 | 细胞名称 | 货号 | 规格 | 单价(元) | 促销价(元) | 立即订购 |
|---|---|---|---|---|---|---|
| 骨髓间充质干细胞 | 胎儿骨髓间充质干细胞 | HUXMF-01001 | 1×106 cells |
6380
|
5104 | |
| 成人骨髓间充质干细胞 | HUXMA-01001 | 1×106 cells |
5480
|
4384 | ||
| SD大鼠骨髓间充质干细胞 | RASMX-01001 | 1×106 cells |
2380
|
1904 | ||
| F344大鼠骨髓间充质干细胞 | RAFMX-01001 | 1×106 cells |
2380
|
1904 | ||
| Wistar大鼠骨髓间充质干细胞 | RAWMX-01001 | 1×106 cells |
2380
|
1904 | ||
| C57BL/6小鼠骨髓间充质干细胞 | MUBMX-01001 | 1×106 cells |
3280
|
2624 | ||
| BALB/c小鼠骨髓间充质干细胞 | MUCMX-01001 | 1×106 cells |
3280
|
2624 | ||
| 兔骨髓间充质干细胞 | RBXMX-01001 | 1×106 cells |
3380
|
2704 | ||
| 狗骨髓间充质干细胞 | CAXMX-01001 | 1×106 cells |
5280
|
4224 | ||
| 脂肪间充质干细胞 | 成人脂肪间充质干细胞 | HUXMD-01001 | 1×106 cells |
5780
|
4624 | |
| SD大鼠脂肪间充质干细胞 | RASMD-01001 | 1×106 cells |
3180
|
2544 | ||
| Wistar大鼠脂肪间充质干细胞 | RAWMD-01001 | 1×106 cells |
3180
|
2544 | ||
| C57BL/6小鼠脂肪间充质干细胞 | MUBMD-01001 | 1×106 cells |
3380
|
2704 | ||
| 兔脂肪间充质干细胞 | RBXMD-01001 | 1×106 cells |
4180
|
3344 | ||
| 狗脂肪间充质干细胞 | CAXMD-01001 | 1×106 cells |
6280
|
5024 | ||
| 胚胎干细胞 | C57BL/6小鼠胚胎干细胞 | MUBES-01001 | 1×106 cells |
2880
|
2304 | |
| 129小鼠胚胎干细胞 | MUAES-01001 | 1×106 cells |
2880
|
2304 | ||
| 神经干细胞 | SD大鼠神经干细胞 | RASNF-01001 | 1×106 cells |
4980
|
3984 | |
| C57BL/6小鼠神经干细胞 | MUBNF-01001 | 1×106 cells |
4980
|
3984 | ||
| 其他干细胞 | 人脐带间充质干细胞 | HUXUC-01001 | 1×106 cells |
6180
|
4944 | |
| 人脐血间充质干细胞 | HUXUB-01001 | 1×106 cells |
6180
|
4944 |
赛业OriCell®在长期细胞研究过程中经过不断优化实验条件,针对各类细胞研发专用的培养基产品,款款皆是精品。其中,诱导分化培养基特别添加能有效改善细胞生长状态的营养物质和针对不同物种特别甄选的优质血清,适合各类干细胞的体外培养,而且针对干细胞多向诱导分化添加了特殊的诱导物质,能高效促进干细胞分化,满足你对干细胞成骨、成脂、成软骨、拟胚体、成神经元、成星形胶质细胞、成肝细胞等多向分化的研究需求。活动期间,任购一款OriCell®培养基产品即可享受八折优惠,机会不常有,一次就购了!
| 产品名称 | 货号 | 规格 | 单价(元) | 促销价(元) | 立即订购 |
|---|---|---|---|---|---|
| 成人骨髓间充质干细胞完全培养基 | HUXMA-90011 | 500mL/kit |
1480
|
1184 | |
| 人骨髓间充质干细胞成骨诱导分化试剂盒 | HUXMX-90021 | 200mL/kit |
1280
|
1024 | |
| 人骨髓间充质干细胞成脂诱导分化试剂盒 | HUXMX-90031 | 100+200mL/kit |
1780
|
1424 | |
| 人骨髓间充质干细胞成软骨诱导分化试剂盒 | HUXMX-90041 | 100mL/kit |
2080
|
1664 | |
| 大鼠骨髓间充质干细胞完全培养基(通用) | RAXMX-90011 | 500mL/kit |
1380
|
1104 | |
| 大鼠骨髓间充质干细胞成骨诱导分化试剂盒 | RAXMX-90021 | 200mL/kit |
1280
|
1024 | |
| 大鼠骨髓间充质干细胞成脂诱导分化试剂盒 | RAXMX-90031 | 100+200mL/kit |
1780
|
1424 | |
| 大鼠骨髓间充质干细胞成软骨诱导分化试剂盒 | RAXMX-90041 | 100mL/kit |
2080
|
1664 | |
| 小鼠骨髓间充质干细胞完全培养基(通用) | MUXMX-90011 | 500mL/kit |
1380
|
1104 | |
| 小鼠骨髓间充质干细胞成骨诱导分化试剂盒 | MUXMX-90021 | 200mL/kit |
1280
|
1024 | |
| 小鼠骨髓间充质干细胞成脂诱导分化试剂盒 | MUXMX-90031 | 100+200mL/kit |
1780
|
1424 | |
| 小鼠骨髓间充质干细胞成软骨诱导分化试剂盒 | MUXMX-90041 | 100mL/kit |
2080
|
1664 | |
| 成人脂肪间充质干细胞完全培养基 | HUXMD-90011 | 500mL/kit |
1480
|
1184 | |
| 人脂肪间充质干细胞成骨诱导分化试剂盒 | HUXMD-90021 | 200mL/kit |
1280
|
1024 | |
| 人脂肪间充质干细胞成脂诱导分化试剂盒 | HUXMD-90031 | 100+200mL/kit |
1780
|
1424 | |
| 人脂肪间充质干细胞成软骨诱导分化试剂盒 | HUXMD-90041 | 100mL/kit |
2080
|
1664 | |
| 大鼠脂肪间充质干细胞完全培养基(通用) | RAXMD-90011 | 500mL/kit |
1380
|
1104 | |
| 大鼠脂肪间充质干细胞成骨诱导分化试剂盒 | RAXMD-90021 | 200mL/kit |
1280
|
1024 | |
| 大鼠脂肪间充质干细胞成脂诱导分化试剂盒 | RAXMD-90031 | 100+200mL/kit |
1780
|
1424 | |
| 大鼠脂肪间充质干细胞成软骨诱导分化试剂盒 | RAXMD-90041 | 100mL/kit |
2080
|
1664 | |
| 小鼠脂肪间充质干细胞完全培养基(通用) | MUXMD-90011 | 500mL/kit |
1380
|
1104 | |
| 小鼠脂肪间充质干细胞成骨诱导分化试剂盒 | MUXMD-90021 | 200mL/kit |
1280
|
1024 | |
| 小鼠脂肪间充质干细胞成脂诱导分化试剂盒 | MUXMD-90031 | 100+200mL/kit |
1780
|
1424 | |
| 小鼠脂肪间充质干细胞成软骨诱导分化试剂盒 | MUXMD-90041 | 100mL/kit |
2080
|
1664 | |
| 血清型小鼠胚胎干细胞完全培养基(通用) | MUXES-90011 | 500mL/kit |
2793
|
2234 | |
| 小鼠胚胎干细胞无血清培养基Ⅰ型(有饲养层) | MUXES-90062 | 500mL/kit |
4536
|
3629 | |
| 小鼠胚胎干细胞无血清培养基Ⅱ型(无饲养层) | MUXES-90061 | 500mL/kit |
4536
|
3629 | |
| 大鼠神经干细胞完全培养基(无血清) | RAXNF-90011 | 100mL/kit |
1380
|
1104 |
赛业OriCell®针对细胞冻存研发的冻存液产品,能大大降低细胞在冻存过程中冰晶对于细胞的损伤,有效提高细胞复苏率和增殖活性,不影响细胞的生长和分化潜能及其它应用。无蛋白、无需程序冻存,细胞可直接置于-80℃冰箱,超高的复苏率(达90%以上),OriCell®无蛋白非程序冻存液堪称细胞冻存神器,你值得拥有!活动期间,任购一款OriCell®冻存液产品即可享受八折优惠!
| 产品名称 | 货号 | 规格(mL) | 单价(元) | 促销价(元) | 立即订购 |
|---|---|---|---|---|---|
| 通用血清型程序冻存液 | CYRO-10001 | 20/50 |
280/560
|
224/448 | |
| hES血清型程序冻存液 | HUXES-07031 | 20/50 |
280/560
|
224/448 | |
| 通用血清型非程序冻存液 | NCRC-10001 | 20/50 |
360/680
|
288/544 | |
| NSC无蛋白程序冻存液 | GUXNX-07031 | 20/50 |
360/680
|
288/544 | |
| NSC无蛋白非程序冻存液 | GUXNX-07021 | 20/50 |
384/720
|
307/576 | |
| 通用型无蛋白非程序冻存液 | NCPF-10001 | 20/50 |
384/720
|
307/576 |
OriCell®拥有种类丰富的细胞因子,针对不同客户的研究需要,提供囊括白介素、生长因子、肿瘤坏死因子、集落刺激因子、干扰素、干扰素、其他因子等几百种细胞因子。OriCell®细胞因子来源于人、小鼠、大鼠、恒河猴、狗、兔、羊、马等多种种属,并提供多种规格,大小分装全满足。所有产品都经过充分的验证与分析,保证其纯度、生物活性和蛋白含量,并严格控制内霉素及微生物污染,确保产品质量及优异的批次稳定性,为你的实验顺利开展保驾护航!活动期间,任购一款OriCell®细胞因子产品即可享受八折优惠,欢迎 咨询订购。
| 类型 | 产品名称 | 货号 | 规格 | 立即订购 |
|---|---|---|---|---|
| 白介素 | 大鼠白介素21 (IL-21) (Rat) | REILP-2101 | 10ug/100ug/500ug/1mg | |
| 小鼠白介素33 (IL-33) (Murine) | MEILP-3301 | 10ug/100ug/500ug/1mg | ||
| 人白介素2 (IL-2) (Human) | HEILP-0201 | 10ug/100ug/500ug/1mg | ||
| 人白介素1α(IL-1α) (Human) | HEILP-0101 | 10ug/100ug/500ug/1mg | ||
| 人白介素8 (72a.a.) (IL-8 (72a.a.)) (Human) | HEILP-0801 | 5ug/100ug/500ug/1mg | ||
| 生长因子 | 小鼠头蛋白(Noggin) (Murine) | MEOPP-1401 | 5ug/100ug/500ug/1mg | |
| 小鼠表皮细胞生长因子(EGF) (Murine) | MEGFP-0501 | 5ug/100ug/500ug/1mg | ||
| 人表皮调节素(EREG) (Human) | HEOPP-0507 | 10ug/100ug/500ug/1mg | ||
| 人表皮生长因子(EGF) (Human) | HEGFP-0501 | 100ug/500ug/1mg | ||
| 肿瘤坏死因子 | 人肿瘤坏死因子α(TNF-α) (Human) | HETNP-0101 | 10ug/100ug/500ug/1mg | |
| 小鼠肿瘤坏死因子α(TNF-α) (Murine) | METNP-0101 | 5ug/100ug/500ug/1mg | ||
| 人B细胞活化因子(BAFF) (Human) | HEOPP-0201 | 5ug/100ug/500ug/1mg | ||
| 集落刺激因子 | 人粒细胞巨噬细胞集落刺激因子(GM-CSF) (Human) | HEOPP-0704 | 5ug/100ug/500ug/1mg | |
| 人干细胞因子(SCF) (Human) | HEOPP-1902 | 10ug/100ug/500ug/1mg | ||
| 小鼠神经胶质成熟因子β(GMF-β) (Murine) | MEOPP-0701 | 10ug/100ug/500ug/1mg | ||
| 干扰素 | 大鼠干扰素γ(IFN-γ) (Rat) | REIFP-0101 | 100ug/500ug/1mg | |
| 小鼠干扰素γ(IFN-γ) (Murine) | MEIFP-0101 | 100ug/500ug/1mg | ||
| 人干扰素ω(IFN-ω) (Human) | HEOPP-0401 | 100ug/500ug/1mg | ||
| 趋化因子 | 小鼠巨噬细胞来源的趋化因子 (MDC/CCL22) (Murine) | MECCP-2201 | 5ug/100ug/500ug/1mg | |
| 小鼠趋化因子CXCL16 (CXCL16) (Murine) | MECXP-1601 | 5ug/100ug/500ug/1mg | ||
| 人趋化因子I-309 (I-309/CCL1) (Human) | HECCP-0101 | 10ug/100ug/500ug/1mg |
赛业OriCell®进口胎牛血清含特级、标准级和去外泌体血清,品质优异,经过多种细胞培养的效果充分验证,好品质看得见,且进口手续齐全,供货稳定,批间一致性更高,确保大家用得省心,买得放心!活动期间,订购同规格OriCell®进口胎牛血清买五送一,不容错过!
● 来源新西兰,血源更优秀,生产工艺更严格。每批胎牛血清均可提供完整的原产地证、质检报告及海关进出口资质,产品安全可追溯。
● 具有极低的内毒素(小于3EU/mL),蛋白含量适中,既能满足细胞生长所需的营养,又不会对细胞造成毒害作用;此外,还对血清中微量元素及多种酶进行了检测,体现了产品检测的全面性。
● 经过多种细胞培养测试,具有优异的性能,适合各类细胞,包括干细胞、原代细胞等各种血清依赖度高的细胞(如胚胎干细胞、骨髓间充质干细胞和星形胶质细胞等)的取材、培养,及其他各类对血清质量有较高要求的实验研究。
● 具有充足的同一批次货存,可将用户不同时间购买的血清差异降到最小,最大程度确保实验研究结果的真实性和可重复性。
| 产品名称 | 货号 | 规格 | 价格(元) | 立即订购 |
|---|---|---|---|---|
| OriCell®特级胎牛血清 | FBSAD-01011-20(Sample) | 20mL | / | |
| FBSAD-01011-100 | 100mL | 2600 | ||
| FBSAD-01011-500 | 500mL | 7688 |
● 正规进口,每批胎牛血清均可提供完整的原产地证、质检报告及海关进出口资质,产品安全可追溯。
● 经过多道分离、纯化、过滤工艺,质地纯净,质量稳定。适合各类常规细胞系如肿瘤细胞的培养、研究。
● 不仅经过了严格的血源筛选,还进行了多种实验验证,检测项目包括成分检测(微生物、内毒素、蛋白含量、主要离子含量等)和性能检测(培养的细胞形态、倍增时间和克隆形成能力等)。OriCell®标准级胎牛血清在所有检测项目中均表现良好。
● 每一批次均经过严格的质量检测以确保品质和批次间稳定性。
| 产品名称 | 货号 | 规格 | 价格(元) | 立即订购 |
|---|---|---|---|---|
| OriCell®标准级胎牛血清 | FBSST-01033-20(Sample) | 20mL | / | |
| FBSST-01033-500 | 500mL | 3188 |
● 超高去除率,通过先进的去外泌体工艺,血清内源外泌体去除率可达99%以上,最大程度减少背景信号的影响,适用于各类对去除外泌体要求严格的研究。
● 甄选OriCell®正规进口的优质胎牛血清作为原料,适合各类细胞,包括干细胞、肿瘤细胞等培养,以及各类对血清质量有较高要求的实验研究。
● 严格质控,经过多种细胞实验测试,可以保持细胞良好的生长活力和增殖能力,并确保微生物、内毒素等质量检测合格。
| 产品名称 | 货号 | 规格 | 价格(元) | 立即订购 |
|---|---|---|---|---|
| OriCell®去外泌体血清 | FBSNE-01061-20 | 20mL | 1200 | |
| FBSNE-01061-50 | 50mL | 2600 |

广西医科大学 冯老师
聊城大学生物制药研究院 张老师

南方医科大学 刘老师

中南大学湘雅三医院 向老师

河北企业客户提供

浙江理工大学,陶老师

客户精选文献
Nat Commun (2021)IF=12.124
Nature Communications (2020)IF=11.878
Bioactive Materials (2021)IF=8.724
Bioactive Materials (2021)IF=8.724
客户精选文献
Journal of Extracellular Vesicles (2021)IF=25.841
Biomaterials (2021)IF=10.317
Acta Biomaterialia (2021)IF=8.974
Bioactive Materials (2021)IF=8.724








